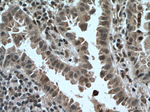
ARMC8 Antibody in Immunohistochemistry (Paraffin) (IHC (P))

Search
Proteintech
ARMC8 Polyclonal Antibody
{{$productOrderCtrl.translations['antibody.pdp.commerceCard.promotion.promotions']}}
{{$productOrderCtrl.translations['antibody.pdp.commerceCard.promotion.viewpromo']}}
{{$productOrderCtrl.translations['antibody.pdp.commerceCard.promotion.promocode']}}: {{promo.promoCode}} {{promo.promoTitle}} {{promo.promoDescription}}. {{$productOrderCtrl.translations['antibody.pdp.commerceCard.promotion.learnmore']}}
产品信息
12653-1-AP
种属反应
宿主/亚型
分类
类型
抗原
偶联物
形式
浓度
规格
纯化类型
保存液
内含物
保存条件
运输条件
产品详细信息
Immunogen sequence: MEVTASSRH YVDRLFDPDP QKVLQGVIDM KNAVIGNNKQ KANLIVLGAV PRLLYLLQQE TSSTELKTEC AVVLGSLAMG TENNVKSLLD CHIIPALLQG LLSPDLKFIE ACLRCLRTIF TSPVTPEELL YTDATVIPHL MALLSRSRYT QEYICQIFSH CCKGPDHQTI LFNHGAVQNI AHLLTSLSYK VRMQALKCFS VLAFENPQVS MTLVNVLVDG ELLPQIFVKM LQRDKPIEMQ LTSAKCLTYM CRAGAIRTDD NCIVLKTLPC LVRMCSKERL LEERVEGAET LAYLIEPDVE LQRIASITDH LIAMLADYFK YPSSVSAITD IKRLDHDLKH AHELRQAAFK L (1-350 aa encoded by BC013424)
靶标信息
ARMC8 is a protein coding gene.
仅用于科研。不用于诊断过程。未经明确授权不得转售。
生物信息学
蛋白别名: Armadillo repeat-containing protein 8; GID complex subunit 5, VID28 homolog; unnamed protein product
基因别名: 1200015K23Rik; ARMC8; GID5; HSPC056; RGD1310477; S863-2; VID28
UniProt ID: (Human) Q8IUR7, (Mouse) Q9DBR3
Entrez Gene ID: (Human) 25852, (Rat) 315949, (Mouse) 74125